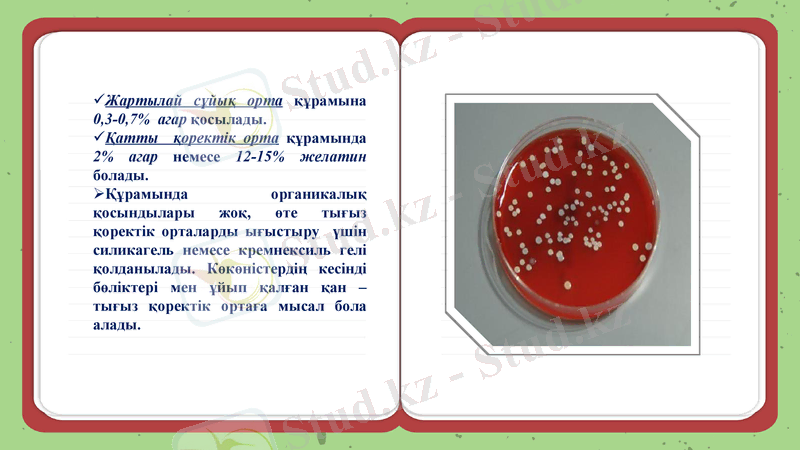
Slide 18

Микроорганизмдер физиологиясы: бактериялардың өсуі, көбеюі және қоректік ортада өсіру



Микроорганизмдер физиологиясы Микроорганизмдердің көбеюі және тіршілік циклі
Орындаған: Мұхтазар А. Б.
Тобы:ХБ-20-1
Қабылдаған: Шолпанқұлова Г. А.

Жоспары
1. Бактерия клеткаларының өсуі
2. Бактерия клеткаларының көбею кезеңдері
3. Микроорганизмдерді қоректік ортада өсіру:
тығыз қоректік ортада және сұйық қоректік ортада өсіру

1. Бактерия клеткаларының өсуі
Бактерияның өсуі
- бұл бөлек торшаның көлемі және массасының ұлғаюы, яғни жасушаның барлық компоненттерінің бір мезгілде келісімді түрде ұлғаюын айтады. Жасушаның өсуі шексіз емес. Ең үлкен өсу деңгейіне жеткен кезде жасуша бөлінеді.

Бактериялардың көпшілігі көлденеңінен екіге бөлінеді.
Грам оң боялатын бактериялардың көпшілігінде бөліну көлденең қалқаның шетінен ортасына қарай синтезделуі арқылы жүреді
Грам теріс боялатын бактериялардың жасушаларының көпшілігінде көбею ортасынан тартылып, екіге бөліну арқылы жүреді.

Бактериялардың өсу фазалары

Әуелгі (1-2 сағ) - бактериялардың клеткаларының саны өзгермейді, аз ғана өседі
Көбеюдің кідіруі (лаг-фаза) - физиологиялық бейімделу кезеңі, жаңа ферменттер индукциясын, рибосоманың жиыны мен синтезін қосады. Бастапқы интенсивті жасушаның өсуі, бірақ бөліну жылдамдығы жоғары емес.
Экспоненциалдық фаза (логарифмдік) - жасушалардың тұрақты түрде максималдық жылдамдықпен бөлінуімен сипатталады. Бұл жылдамдық бактерия мен жылдамдық түріне байланысты болады. Бактериялардың арту уақыты генерациялану уақыты деп аталады, бұл уақыт бактерия түріне байланысты әртүрлі болады. Мыс: псевдоманад-14 мин, туберкулез таяқшасы-24 сағ.
Өсу жылдамдығының азаюы (2 сағ) - бактериальді жасушалардың активтілігінің төмендеуі және генерация кезеңінің ұзаруы ортада қоректік заттардың азаюынан болады, онда метаболизм өнімдерінің көбеюі және дақылдың ескіруі болады;
Тұрақты (стационарлы) (2 сағ) - тыныштық кезеңінде пайда болған және өлген жасушалардың саны арасындағы тепе-теңдік болады. Спора түзетін бактериялар (бациллалар, клостридиялар) споруляция кезеңіне өте алады;
Өлімнің жылдамдауы (бірнеше сағаттан, бірнеше аптаға дейін) ;
Логарифмдік өлім (3 сағ) ;
Өлімнің жылдамдылығының тежелу фазасы.

2. Бактерия клеткаларының көбею кезеңдері

Бактерияның көбеюі
- микроорганизмдердің
саны жағынан ұлғаюы,
өсіндінің қайта жаңару
қабілеттілігі.
- бактериялар бөліну
арқылы көбейеді. Бөліну
кезінде клетканың
ортасынан біртіндеп
қалқанша пайда болып,
клетка ішіндегі заттарды
екіге бөледі

Бактериялар бөліну арқылы көбейеді. Бөліну кезінде клетканың ортасынан біртіндеп қалқанша пайда болып, клетка ішіндегі заттарды екіге бөледі. Микробактериялардың кейбір түрлерінде бұл байқалмайды. Бәлінудің соңғы түрі, ересек бактерияларда байқалады
Егер таяқша тәрізді клеткалар бөлінгенде өз ара тең екі клетка пайда болса, оны изоморфты бөліну деп
клетка бірдей тен, екіге бөлІнбей бөліктері әр түрлі болса - гетероморфты бөліну деп атайды

Бактериялардың көбеюі
Жынысты
Жыныссыз
Вегетативті

Жынысты
Екі клетканың бір-бірімен түйісуінің нәтижесінде жүреді.
Жыныссыз
Спора түзу арқылы жүзеге асады.
Вегетативті
Клетканың жай ғана екіге бөлінуі арқылы жүреді.

Бұл кезде ортадағы бактерияның коректік заттары таусылады. Ұзақтығы түрлі микроорганизмдер үшін түрліше болып келеді.


Споралардың түзілуі, формасы, төзімділігі
Споралар- жасуша қабырғасының грам- оң сияқты, тыныштық жағдайдағы жағдайдағы бактериялардың өзгеше формасы.
Спора бактерияның тіршілік етуіне қолайсыз жағдайлар туған кезде түзіледі. Бактерия жасушасының ішінде бір спора түзіледі.

Споралардың формасы

Қоректік орта
Тығыз
Сұйық

Сұйық қоректік орта
Құрамына 0, 5%-ға дейін агар-агар қосылады.
Алу көзі: Жалпы агар немесе агар-агар - кейбір қызыл теңіз балдырларынан алынатын полисахаридтер қоспасы болып табылады.
Қолдану мақсаты: Микроорганизмдер мен бактерияларды өсіру үшін дақылдық орта дайындауда қолданылады. Ең алғаш 1883 жылы Кохтың зертханасында тығыз қоректік орта алу үшін агар қолданылған болатын.
Жартылай сұйық орта құрамына 0, 3-0, 7% агар қосылады.
Қатты қоректік орта құрамында 2% агар немесе 12-15% желатин болады.
Құрамында органикалық қосындылары жоқ, өте тығыз қоректік орталарды ығыстыру үшін силикагель немесе кремнексиль гелі қолданылады. Көкөністердің кесінді бөліктері мен ұйып қалған қан - тығыз қоректік ортаға мысал бола алады.

Тығыз - сұйық қоректік ортадан дайындалады, оған гельді агенттер - агар немесе желатин қосылады. Тығыз орталар микроорганизмдердің таза дақылдарын бөліп алу үшін, диагностикалық мақсатта, микроорганизмдерді сандық есепке алу, анықтау, протеолитикалық және антагонистік белсенділік үшін қолданылады.
Қатты қоректік орта құрамында 2% агар немесе 12-15% желатин болады.
Құрамында органикалық қосындылары жоқ, өте тығыз қоректік орталарды ығыстыру үшін силикагель немесе кремнексиль гелі қолданылады. Көкөністердің кесінді бөліктері мен ұйып қалған қан - тығыз қоректік ортаға мысал бола алады.
- Іс жүргізу
- Автоматтандыру, Техника
- Алғашқы әскери дайындық
- Астрономия
- Ауыл шаруашылығы
- Банк ісі
- Бизнесті бағалау
- Биология
- Бухгалтерлік іс
- Валеология
- Ветеринария
- География
- Геология, Геофизика, Геодезия
- Дін
- Ет, сүт, шарап өнімдері
- Жалпы тарих
- Жер кадастрі, Жылжымайтын мүлік
- Журналистика
- Информатика
- Кеден ісі
- Маркетинг
- Математика, Геометрия
- Медицина
- Мемлекеттік басқару
- Менеджмент
- Мұнай, Газ
- Мұрағат ісі
- Мәдениеттану
- ОБЖ (Основы безопасности жизнедеятельности)
- Педагогика
- Полиграфия
- Психология
- Салық
- Саясаттану
- Сақтандыру
- Сертификаттау, стандарттау
- Социология, Демография
- Спорт
- Статистика
- Тілтану, Филология
- Тарихи тұлғалар
- Тау-кен ісі
- Транспорт
- Туризм
- Физика
- Философия
- Халықаралық қатынастар
- Химия
- Экология, Қоршаған ортаны қорғау
- Экономика
- Экономикалық география
- Электротехника
- Қазақстан тарихы
- Қаржы
- Құрылыс
- Құқық, Криминалистика
- Әдебиет
- Өнер, музыка
- Өнеркәсіп, Өндіріс
Қазақ тілінде жазылған рефераттар, курстық жұмыстар, дипломдық жұмыстар бойынша біздің қор #1 болып табылады.



Ақпарат
Қосымша
Email: info@stud.kz